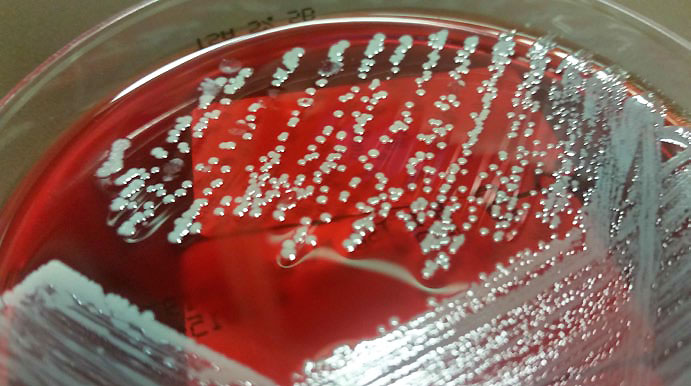
So sehen Staphylococcus aureus Bakterien-Kolonien aus. Im Labor werden die Bakterien auf speziellen N&auml;hrb&ouml;den gez&uuml;chtet.

Wie gelangen Bakterien in unseren Körper? Und wie lösen sie dort Infektionen aus? Für das Bakterium Staphylococcus aureus, das neben harmlosen Infektionen auch Blutvergiftungen verursacht, kann die Wissenschaft diese Fragen nun beantworten.

Die Haut ist unser Schutzmantel. Ist sie verletzt, können Erreger in den Körper eindringen – auch Staphylococcus aureus.
DLR PT / BMBF
Die Haut ist unser Schutzmantel. Sie schützt uns vor äußeren Umwelteinflüssen, vor Allergenen und Krankheitserregern. Ist die Haut jedoch verletzt, können Erreger in den Körper eindringen. Einer dieser „Übeltäter“ ist das Bakterium Staphylococcus aureus. „Es ist ganz natürlich, dass solche Staphylokokken sich auf unserer Haut ansiedeln“, sagt Professor Dr. Mathias Herrmann, Infektionsmediziner am Universitätsklinikum des Saarlandes. Sie können zwar Hautinfektionen, wie zum Beispiel Haarbalg-Entzündungen, auslösen. Diese sind jedoch meist harmlos und selbstheilend. „Problematisch wird es erst, wenn Staphylokokken in den Körper eindringen. Dort können sie zu Entzündungen von Wunden, schweren Eiterungen und sogar zu einer Blutvergiftung führen“, beschreibt Herrmann. Ein weiteres Problem ist: Staphylokokken sind sehr anpassungsfähig und oftmals antibiotikaresistent. Besonders berüchtigt ist der methicillinresistente Staphylococcus aureus, der Krankenhauskeim MRSA. Für den Forschungsverbund SkinStaph – eine Fördermaßnahme des Bundesministeriums für Bildung und Forschung – Gründe genug, die Erkrankungsmechanismen von Staphylococcus-aureus-Infektionen genauer zu erforschen.

Ein Blick durch das Lichtmikroskop verrät, dass diese Blutprobe Staphylococcus aureus (kleine dunkle Punkte) enthält.
Universitätsklinikum des Saarlandes
Mehr als nur ein Türöffner: das Protein Eap
Der Schlüssel zum Verständnis von Staphylokokken-Infektionen ist für Herrmann ein Protein, das die Bakterien auf ihrer Oberfläche tragen: das extrazelluläre Adhäsiv-Protein, kurz Eap. „Bislang gingen wir davon aus, dass Eap den Bakterien nur dabei hilft, sich an die Hautzellen ihres Wirts, also beispielsweise an menschlichen Hautzellen, anzuheften“, erklärt Herrmann. Doch offensichtlich geht seine krank machende Bedeutung deutlich über diese ursprünglich bekannte Wirkung hinaus. Gemeinsam mit seinem Institutskollegen Privatdozent Dr. Markus Bischoff, dem Gießener Biochemiker Professor Klaus Preissner sowie mit Wissenschaftlerinnen und Wissenschaftlern des Universitätsklinikums Utrecht um Professorin Suzan Rooijakkers und der Universität Missouri um Professor Brian Geisbrecht hat der Forschungsverbund herausgefunden, dass Eap den Bakterien – durch verschiedene Mechanismen – optimale Bedingungen für eine Infektion schafft.
Zunächst öffnet Eap den Staphylokokken die „Tür“ zu verschiedenen menschlichen Zellen, beispielsweise Hautzellen. Mithilfe des Oberflächenproteins Eap gelangen die Bakterien ins Innere der Zellen. „In dieser geschützten Umgebung können sich die Staphylokokken dann vermehren – unerkannt von den Abwehrreaktionen des Körpers“, beschreibt Herrmann. Aber damit nicht genug: Siedeln sich die Staphylokokken in einer Wunde an, hemmt Eap dort ganz gezielt die Neubildung von Hautzellen und kleinsten Blutgefäßen. „Doch genau diese neu gebildeten Hautzellen und Blutgefäße sind für die Wundheilung entscheidend“, erklärt Herrmann. „Eap ist also der Grund, warum infizierte Hautwunden schlecht heilen!“
So sehen Staphylococcus aureus Bakterien-Kolonien aus. Im Labor werden die Bakterien auf speziellen Nährböden gezüchtet.
Universitätsklinikum des Saarlandes
Immunsystem wird aktiv beeinflusst
Neueste Ergebnisse des SkinStaph-Verbundes zeigen, dass Eap zudem in der Lage ist, die Abwehrmechanismen des Wirts direkt und aktiv zu schwächen. „Bislang ging man davon aus, dass Staphylococcus- aureus-Erreger den befallenen Organismus direkt durch Gewebeenzyme und Toxine schädigen“, so Herrmann. Bischoff ergänzt: „Jetzt haben wir eine bislang unbekannte Wechselwirkung zwischen den Eap-Proteinen der Staphylokokken und bestimmten Eiweiß spaltenden Enzymen in weißen Blutkörperchen entdeckt, den neutrophilen Proteasen.“ Neutrophile Proteasen spielen eine entscheidende Rolle bei der Immunabwehr: Sie können Bakterien direkt abtöten, aber auch krank machende bakterielle Faktoren inaktivieren und die Immunantwort beeinflussen. Durch die Wechselwirkung mit Eap verlieren die Proteasen allerdings ihre Fähigkeit, Eiweiße zu spalten – und damit ihre Funktion in der Immunabwehr. „Im Rahmen dieses Kooperationsprojekts konnten wir Eap-Moleküle erstmals als neue Klasse von Protease- Inhibitoren beschreiben, die für die ‚intelligente‘ Hemmung der Wirtsabwehr verantwortlich sind“, erläutert Herrmann. So schädlich Eap etwa für die Heilung chronischer Wunden sein kann, so hilfreich könnten die Fähigkeiten des Proteins für Krankheiten sein, bei denen es zu einer überschießenden Immunreaktion kommt. Den Ausblick zu diesen Arbeiten formuliert Preissner: „Eap-Proteine könnten eine neue Klasse von Substanzen gegen chronisch immunologische Krankheiten darstellen. Wir werden die Proteine auch in Zukunft genau unter die Lupe nehmen.“
Literatur: Stapels DAC, Ramyar KX, Bischoff M, von Köckritz-Blickwede M, Milder FJ, Ruyken M, Eisenbeis J, McWhorter WJ, Herrmann M, van Kessel KPM, Geisbrecht BJ, Rooijakkers SH. Staphylococcus aureus secretes a unique class of neutrophil serine protease inhibitors. Proc Natl Acad Sci USA 2014;111:13187-92
Ansprechpartner:
Prof. Dr. Mathias Herrmann
PD Dr. Markus Bischoff
Institut für Medizinische Mikrobiologie und Hygiene
Universitätsklinikum des Saarlandes
Kirrberger Straße
66421 Homburg/Saar
06841 16-23900
06841 16-23985
mathias.herrmann@uks.eu